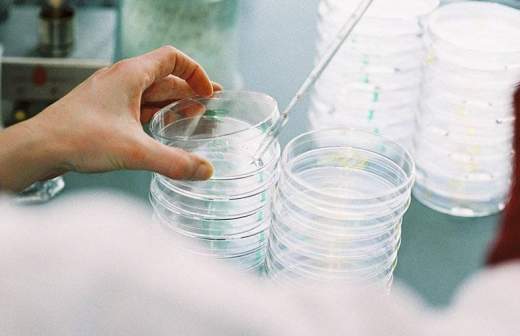

В Южной Корее убили более 200 тыс. птиц для сдерживания птичьего гриппа

В Южной Корее введен карантин из-за распространения птичьего гриппа. За минувший месяц в стране было уничтожено более 200 тыс. птиц, чтобы сдержать распространение заболевания.
Власти южнокорейского государства пошли на радикальные меры после обнаружения патогенного штамма на четырех фермах по разведению уток.
В период с 18 ноября по 22 декабря в стране уничтожили более 200 тыс. уток, передает телеканал RT со ссылкой на зарубежные СМИ.
Аналогичные меры предпринимались в стране в прошлом году. Тогда было забито более 300 млн птиц.
Вирус H5N6 — инфекционное заболевание птиц, зачастую протекающее без очевидных симптомов. Кроме того, вирус способен преодолевать видовой барьер и вызывать болезнь или инфекции у людей и животных.